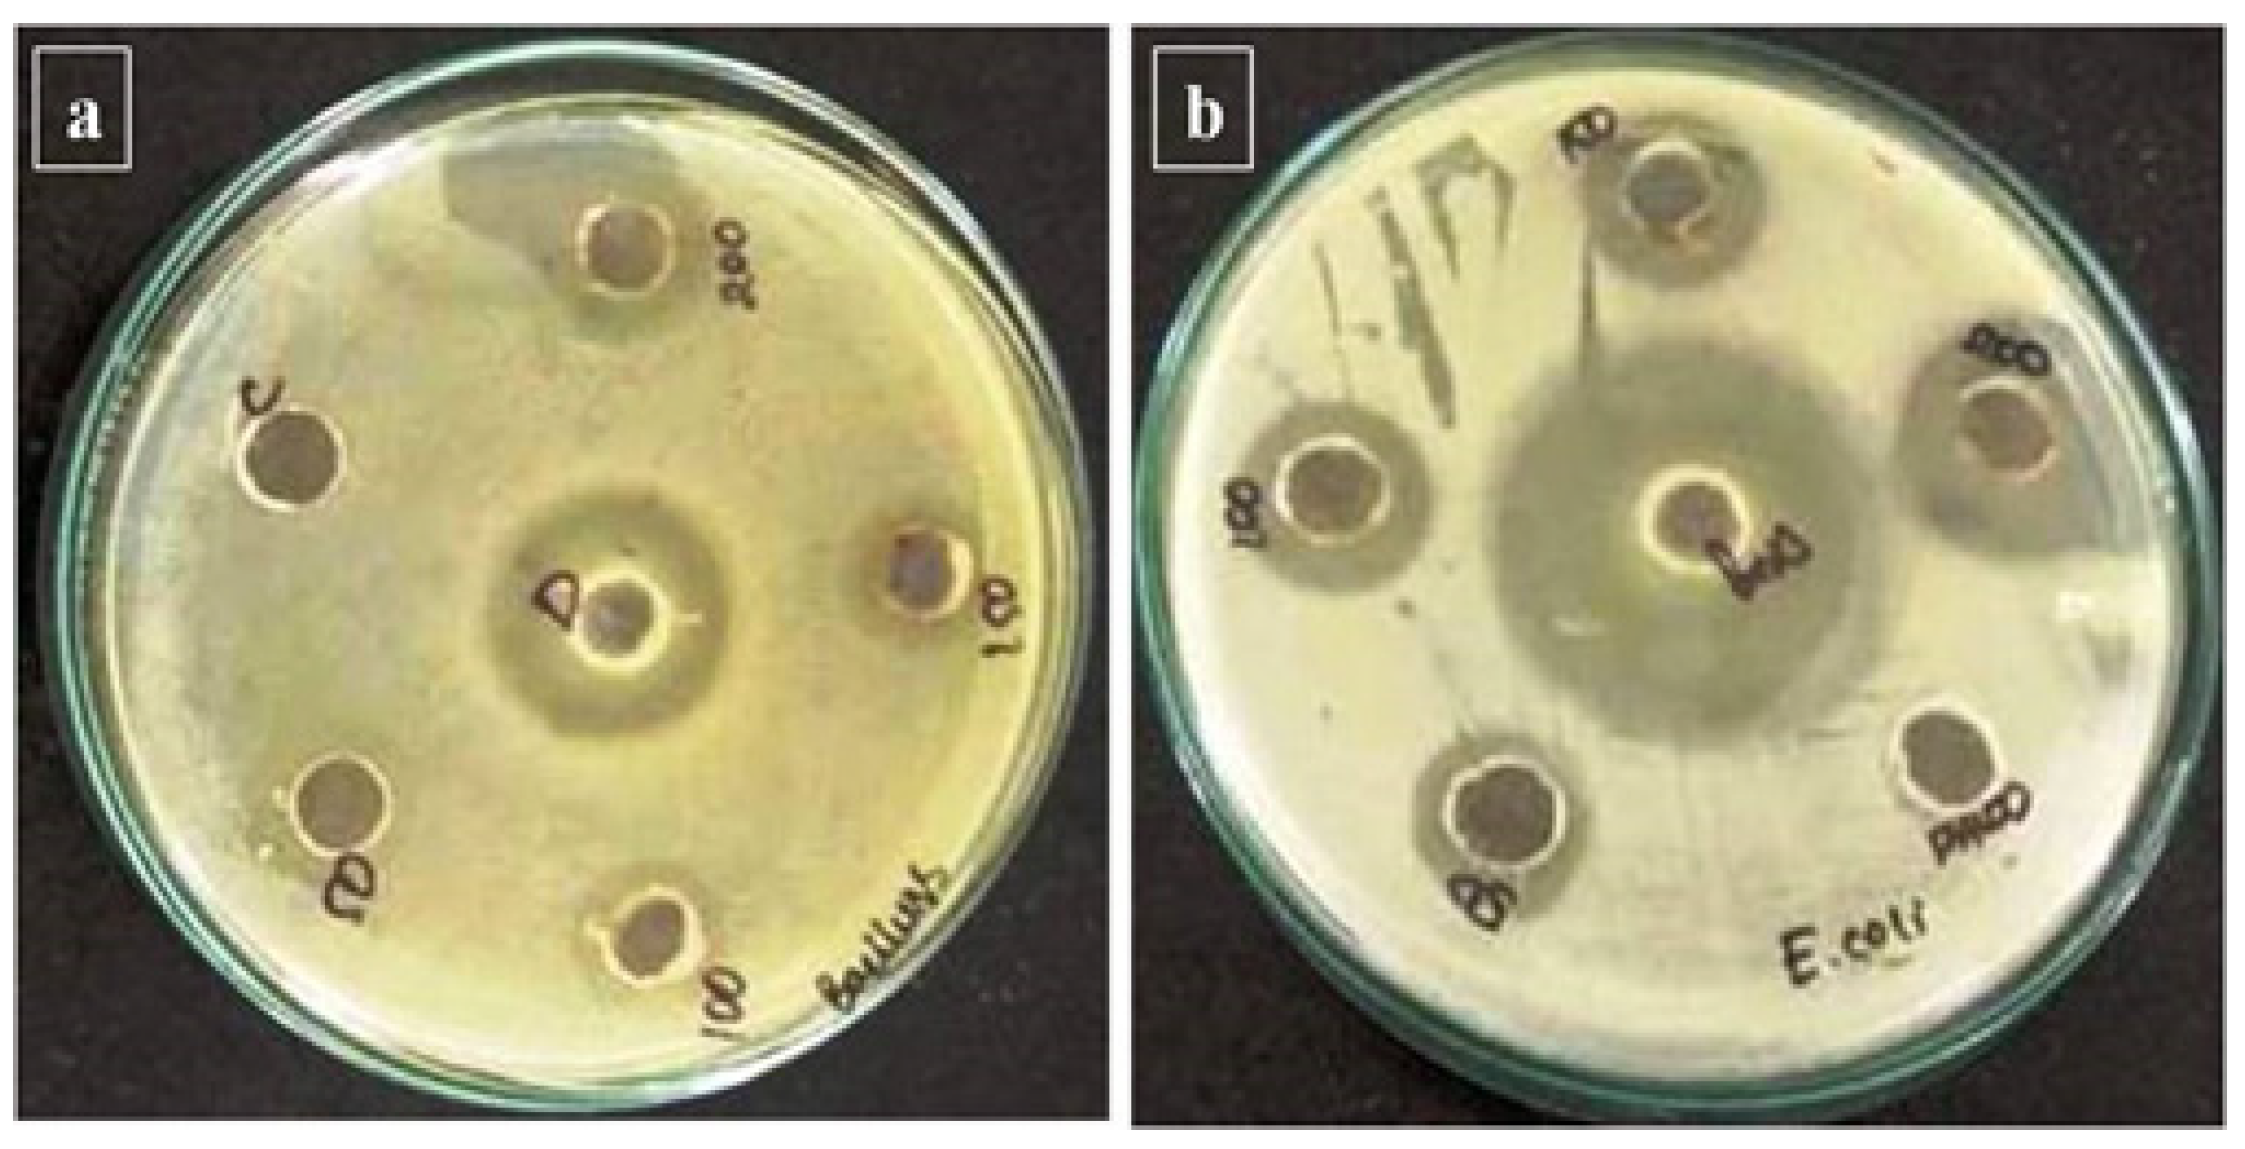
Nanomaterials 12 02393 g005

Sustainable Green Synthesis of Yttrium Oxide (Y2O3) Nanoparticles Using Lantana camara Leaf Extracts: Physicochemical Characterization, Photocatalytic Degradation, Antibacterial, and Anticancer Potency
Abstract
1. Introduction
2. Materials and Methods
2.1. Chemicals and Reagents
2.2. Preparation of Leaf Extracts
2.3. Y2O3 Nanoparticles Synthesis and Characterization
2.4. Photocatalytic Evaluation
2.5. Antibacterial Activity
2.6. Cytotoxicity Assay
2.7. In Vitro Drug Release
3. Results
3.1. Characterization of LC Y2O3 NPs
3.2. Photocatalytic Activity of Green Synthesized LC Y2O3 NPs
3.3. Green-Synthesized LC Y2O3 NPs Antibacterial Activity
3.4. Cytotoxicity of Y2O3 NPs in HeLa Cell Lines
3.5. In Vitro Drug Release
4. Conclusions
Author Contributions
Funding
Institutional Review Board Statement
Informed Consent Statement
Data Availability Statement
Acknowledgments
Conflicts of Interest
References
- Andleeb, A.; Andleeb, A.; Asghar, S.; Zaman, G.; Tariq, M.; Mehmood, A.; Nadeem, M.; Hano, C.; Lorenzo, J.M.; Abbasi, B.H. A systematic review of biosynthesized metallic nanoparticles as a promising anti-cancer-strategy. Cancers 2021, 13, 2818. [Google Scholar] [CrossRef] [PubMed]
- Sung, H.; Ferlay, J.; Siegel, R.L.; Laversanne, M.; Soerjomataram, I.; Jemal, A.; Bray, F. Global Cancer Statistics 2020: GLOBOCAN Estimates of Incidence and Mortality Worldwide for 36 Cancers in 185 Countries. CA Cancer J. Clin. 2021, 71, 209–249. [Google Scholar] [CrossRef] [PubMed]
- Al Sufyani, M.N.; Hussien, N.A.; Hawsawi, Y.M. Characterization and Anticancer Potential of Silver Nanoparticles Biosynthesized from Olea chrysophylla and Lavandula dentata Leaf Extracts on HCT116 Colon Cancer Cells. J. Nanomater. 2019, 2019, 7361695. [Google Scholar] [CrossRef]
- Ratan, Z.A.; Haidere, M.F.; Nurunnabi, M.; Shahriar, S.M.; Ahammad, A.J.; Shim, Y.Y.; Reaney, M.J.; Cho, J.Y. Green chemistry synthesis of silver nanoparticles and their potential anticancer effects. Cancers 2020, 12, 855. [Google Scholar] [CrossRef]
- Sudhakar, A. History of cancer, ancient and modern treatment methods. J. Cancer Sci. Ther. 2009, 1, 1–4. [Google Scholar] [CrossRef]
- AbuMousa, R.A.; Baig, U.; Gondal, M.A.; Dastageer, M.A.; AlSalhi, M.S.; Moftah, B.; Alqahtani, F.Y.; Akhter, S.; Aleanizy, F.S. Investigation of the survival viability of cervical cancer cells (HeLa) under visible light-induced photo-catalysis with facile synthesized WO3/ZnO nanocomposite. Saudi J. Biol. Sci. 2020, 27, 1743–1752. [Google Scholar] [CrossRef]
- Islami, F.; Miller, K.D.; Siegel, R.L. National and state estimates of lost earnings from cancer deaths in the United States. JAMA Oncol. 2019, 5, e191460. [Google Scholar] [CrossRef]
- Fontham, E.T.; Wolf, A.M.; Church, T.R.; Etzioni, R.; Flowers, C.R.; Herzig, A.; Guerra, C.E.; Oeffinger, K.C.; Shih, Y.C.T.; Walter, L.C.; et al. Cervical cancer screening for individuals at average risk: 2020 guideline update from the American Cancer Society. CA Cancer J. Clin. 2020, 70, 321–346. [Google Scholar] [CrossRef]
- Ding, W.; Liang, Z.; El-Kott, A.F.; El-Kenawy, A.E. Investigation of anti-human ovarian cancer effects of decorated Au nanoparticles on Thymbra spicata extract modified Fe3O4 nanoparticles. Arab. J. Chem. 2021, 14, 103205. [Google Scholar] [CrossRef]
- Chen, J.; Li, Y.; Fang, G.; Cao, Z.; Shang, Y.; Alfarraj, S.; Alharbi, S.A.; Li, J.; Yang, S.; Duan, X. Green synthesis, characterization, cytotoxicity, antioxidant, and anti-human ovarian cancer activities of Curcumae kwangsiensis leaf aqueous extract green-synthesized gold nanoparticles. Arab. J. Chem. 2021, 14, 103000. [Google Scholar] [CrossRef]
- Aka, E.K.; Horo, A.; Fanny, M.; Koffi, A.; Olou, L.; Konan, P.; Toure-Ecra, A.; Kone, M. The delay, symptoms, and survival of Ivorian adolescent girls and young adults with uterine cervical cancer. Gynecol. Obstet. Clin. Med. 2021, 1, 153–159. [Google Scholar] [CrossRef]
- Monge-Fuentes, V.; Muehlmann, L.A.; de Azevedo, R.B. Perspectives on the application of nanotechnology in photodynamic therapy for the treatment of melanoma. Nano Rev. 2014, 5, 24381. [Google Scholar] [CrossRef] [PubMed]
- Vinardell, M.P.; Mitjans, M. Nanocarriers for delivery of antioxidants on the skin. Cosmetics 2015, 2, 342–354. [Google Scholar] [CrossRef]
- Prabhakar, U.; Maeda, H.; Jain, R.K.; Sevick-Muraca, E.M.; Zamboni, W.; Farokhzad, O.C.; Barry, S.T.; Gabizon, A.; Grodzinski, P.; Blakey, D.C. Challenges and key considerations of the enhanced permeability and retention effect for nanomedicine drug delivery in oncology. Cancer Res. 2013, 73, 2412–2417. [Google Scholar] [CrossRef]
- Elveny, M.; Khan, A.; Nakhjiri, A.T.; Albadarin, A.B. A state-of-the-art review on the application of various pharmaceutical nanoparticles as a promising technology in cancer treatment. Arab. J. Chem. 2021, 14, 103352. [Google Scholar] [CrossRef]
- Rajakumar, G.; Mao, L.; Bao, T.; Wen, W.; Wang, S.; Gomathi, T.; Gnanasundaram, N.; Rebezov, M.; Shariati, M.A.; Chung, I.M.; et al. Yttrium oxide nanoparticle synthesis: An overview of methods of preparation and biomedical applications. Appl. Sci. 2021, 11, 2172. [Google Scholar] [CrossRef]
- Ramana, C.V.; Atuchin, V.V.; Kesler, V.G.; Kochubey, V.A.; Pokrovsky, L.D.; Shutthanandan, V.; Becker, U.; Ewing, R.C. Growth and surface characterization of sputter-deposited molybdenum oxide thin films. Appl. Surf. Sci. 2007, 253, 5368–5374. [Google Scholar] [CrossRef]
- Rahman, M.; Kazmi, I.; Beg, S.; Hafeez, A.; Afzal, M.; Kumar, V.; Anwar, F.; Ahmad, F.J. Functionalized graphene-based nanomaterials for drug delivery and biomedical applications in cancer chemotherapy. In Nano Pharmacother; William Andrew Publishing: Norwich, NY, USA, 2019; Volume 13, pp. 429–460. [Google Scholar] [CrossRef]
- Ramana, C.V.; Carbajal-Franco, G.; Vemuri, R.S.; Troitskaia, I.B.; Gromilov, S.A.; Atuchin, V.V. Optical properties and thermal stability of germanium oxide (GeO2) nanocrystals with α-quartz structure. Mater. Sci. Eng. B 2010, 174, 279–284. [Google Scholar] [CrossRef]
- Augustine, R.; Dalvi, Y.B.; Nath, V.Y.; Varghese, R.; Raghuveeran, V.; Hasan, A.; Thomas, S.; Sandhyarani, N. Yttrium oxide nanoparticle loaded scaffolds with enhanced cell adhesion and vascularization for tissue engineering applications. Mater. Sci. Eng. C 2019, 103, 109801. [Google Scholar] [CrossRef]
- Augustine, R.; Dan, P.; Sosnik, A. Electrospun poly (vinylidene fluoride-trifluoroethylene)/zinc oxide nanocomposite tissue engineering scaffolds with enhanced cell adhesion and blood vessel formation. Nano Res. 2017, 10, 3358–3376. [Google Scholar] [CrossRef]
- Xia, Y.; Chen, H.; Zhang, F.; Wang, L.; Chen, B.; Reynolds, M.A.; Ma, J.; Schneider, A.; Gu, N.; Xu, H.H. Injectable calcium phosphate scaffold with iron oxide nanoparticles to enhance osteogenesis via dental pulp stem cells. Artif. Cells Nanomed. Biotechnol. 2018, 46, 423–433. [Google Scholar] [CrossRef] [PubMed]
- Garg, V.; Sengar, B.S.; Awasthi, V.; Kumar, A.; Singh, R.; Kumar, S.; Mukherjee, C.; Atuchin, V.V.; Mukherjee, S. Investigation of Dual-Ion Beam Sputter-Instigated Plasmon Generation in TCOs: A Case Study of GZO. ACS Appl. Mater. Interfaces 2018, 10, 5464–5474. [Google Scholar] [CrossRef] [PubMed]
- Dyshlyuk, L.; Babich, O.; Ivanova, S.; Vasilchenco, N.; Atuchin, V.; Korolkov, I.; Russakov, D.; Prosekov, A. Antimicrobial potential of ZnO, TiO2 and SiO2 nanoparticles in protecting building materials from biodegradation. Int. Biodeterior. Biodegrad. 2020, 146, 104821. [Google Scholar] [CrossRef]
- Augustine, R.; Dominic, E.A.; Reju, I.; Kaimal, B.; Kalarikkal, N.; Thomas, S. Investigation of angiogenesis and its mechanism using zinc oxide nanoparticle-loaded electrospun tissue engineering scaffolds. RSC Adv. 2014, 4, 51528–51536. [Google Scholar] [CrossRef]
- Ahtzaz, S.; Nasir, M.; Shahzadi, L.; Amir, W.; Anjum, A.; Arshad, R.; Iqbal, F.; Chaudhry, A.A.; Yar, M.; ur Rehman, I. A study on the effect of zinc oxide and zinc peroxide nanoparticles to enhance angiogenesis-pro-angiogenic grafts for tissue regeneration applications. Mater. Des. 2017, 132, 409–418. [Google Scholar] [CrossRef]
- Athinarayanan, J.; Periasamy, V.S.; Alshatwi, A.A. Eco-friendly synthesis and characterization of platinum-copper alloy nanoparticles induce cell death in human cervical cancer cells. Process Biochem. 2016, 51, 925–932. [Google Scholar] [CrossRef]
- Perveen, A.; Molardi, C.; Fornaini, C. Applications of laser welding in dentistry: A state-of-the-art review. Micromachines 2018, 9, 209. [Google Scholar] [CrossRef]
- Thompson, L.A.; Darwish, W.S. Environmental chemical contaminants in food: Review of a global problem. J. Toxicol. 2019, 2019, 2345283. [Google Scholar] [CrossRef]
- Bahrulolum, H.; Nooraei, S.; Javanshir, N. Green synthesis of metal nanoparticles using microorganisms and their application in the agri-food sector. J. Nanotech. 2021, 19, 86. [Google Scholar] [CrossRef]
- Nagajyothi, P.C.; Cha, S.J.; Yang, I.J.; Sreekanth, T.V.; Kim, K.J.; Shin, H.M. Antioxidant and anti-inflammatory activities of zinc oxide nanoparticles synthesized using Polygala tenuifolia root extract. J. Photochem. Photobiol. B Biol. 2015, 146, 10–17. [Google Scholar] [CrossRef]
- Wu, P.; Song, Z.; Wang, X.; Li, Y.; Li, Y.; Cui, J.; Tuerhong, M.; Jin, D.Q.; Abudukeremu, M.; Lee, D.; et al. Bioactive triterpenoids from Lantana camara showing anti-inflammatory activities in vitro and in vivo. Bioorg. Chem. 2020, 101, 104004. [Google Scholar] [CrossRef] [PubMed]
- SujimaAnbu, A.; Velmurugan, P.; Lee, J.H.; Oh, B.T.; Venkatachalam, P. Biomolecule-loaded chitosan nanoparticles induce apoptosis and molecular changes in cancer cell line (SiHa). Int. J. Biol. Macromol. 2016, 88, 18–26. [Google Scholar] [CrossRef] [PubMed]
- Ramana, C.V.; Mudavakkat, V.H.; Bharathi, K.K.; Atuchin, V.V.; Pokrovsky, L.D.; Kruchinin, V.N. Enhanced optical constants of nanocrystalline yttrium oxide thin films. Appl. Phys. Lett. 2011, 98, 031905. [Google Scholar] [CrossRef]
- Hussain, A.I.; Anwar, F.; Rasheed, S.; Nigam, P.S.; Janneh, O.; Sarker, S.D. Composition, antioxidant and chemotherapeutic properties of the essential oils from two Origanum species growing in Pakistan. Rev. Bras. Farmacogn. 2011, 21, 943–952. [Google Scholar] [CrossRef]
- Sathish, R.; Vyawahare, B.; Natarajan, K. Antiulcerogenic activity of Lantana camara leaves on gastric and duodenal ulcers in experimental rats. J. Ethnopharmacol. 2011, 134, 195–207. [Google Scholar] [CrossRef]
- Barros, L.M.; Duarte, A.E.; Morais-Braga, M.F.B.; Waczuk, E.P.; Vega, C.; Leite, N.F.; Alencar de Menezes, I.R.; Coutinho, H.D.M.; Rocha, J.B.T.; Kamdem, J.P. Chemical characterization and trypanocidal, leishmanicidal and cytotoxicity potential of Lantana camara L. (Verbenaceae) essential oil. Molecules 2016, 21, 209. [Google Scholar] [CrossRef]
- Venkatachalam, T.; Kumar, V.K.; Selvi, P.K.; Maske, A.O.; Anbarasan, V.; Kumar, P.S. Antidiabetic activity of Lantana camara Linn fruits in normal and streptozotocin-induced diabetic rats. J. Pharm. Res. 2011, 4, 1550–1552. [Google Scholar]
- Garg, S.K.; Shah, M.A.; Garg, K.M.; Farooqui, M.M.; Sabir, M. Antilymphocytic and immunosuppressive effects of Lantana camara leaves in rats. Indian J. Exp. Biol. 1997, 35, 1315–1328. [Google Scholar]
- Patil, S.P.; Kumbhar, S.T. Evaluation of terpene-rich extract of Lantana camara L. leaves for antimicrobial activity against mycobacteria using Resazurin Microtiter Assay (REMA). Beni-Suef Univ. J. Basic Appl. Sci. 2018, 7, 511–515. [Google Scholar] [CrossRef]
- Setua, S.; Menon, D.; Asok, A.; Nair, S.; Koyakutty, M. Folate receptor targeted rare-earth oxide nanocrystals for bi-modal fluorescence and magnetic imaging of cancer cells. Biomaterials 2010, 31, 714–729. [Google Scholar] [CrossRef]
- Srinivasan, R.; Rajeswari Yogamalar, N.; Elanchezhiyan, J.; Justin Joseyphus, R.; Chandra Bose, A. Structural and optical properties of europium doped yttrium oxide nanoparticles for phosphor applications. J. Alloys Compd. 2010, 496, 472–477. [Google Scholar] [CrossRef]
- Luca, A.D.; Kenel, C.; Pado, J.; Joglekar, S.S.; Dunand, D.C.; Leinenbach, C. Thermal stability and influence of Y2O3 dispersoids on the heat treatment response of an additively manufactured ODS Ni–Cr–Al–Ti γ/γ′ superalloy. J. Mater. Res. Technol. 2021, 15, 2883–2898. [Google Scholar] [CrossRef]
- Rubio, E.J.; Atuchin, V.V.; Kruchinin, V.N.; Pokrovsky, L.D.; Prosvirin, I.P.; Ramana, C.V. Electronic Structure and Optical Quality of Nanocrystalline YO Film Surfaces and Interfaces on Silicon. J. Phys. Chem. C 2014, 118, 13644–13651. [Google Scholar] [CrossRef]
- Gizowska, M.; Piątek, M.; Perkowski, K.; Konopka, G.; Witosławska, I. Fabrication of Nanoyttria by method of solution combustion synthesis. Nanomaterials 2020, 10, 831. [Google Scholar] [CrossRef]
- Hosseini, S.F.; Zandi, M.; Rezaei, M.; Farahmandghavi, F. Two-step method for encapsulation of oregano essential oil in chitosan nanoparticles: Preparation, characterization and in vitro release study. Carbohydr. Polym. 2013, 95, 50–56. [Google Scholar] [CrossRef] [PubMed]
- Khaksar, M.R.; Rahimifard, M.; Baeeri, M.; Maqbool, F.; Navaei-Nigjeh, M.; Hassani, S.; Moeini-Nodeh, S.; Kebriaeezadeh, A.; Abdollahi, M. Protective effects of cerium oxide and yttrium oxide nanoparticles on reduction of oxidative stress induced by sub-acute exposure to diazinon in the rat pancreas. J. Trace Elem. Med. Biol. 2017, 41, 79–90. [Google Scholar] [CrossRef]
- Kambale, E.K.; Nkanga, C.I.; Mutonkole, B.P.I.; Bapolisi, A.M.; Tassa, D.O.; Liesse, J.M.I.; Krause, R.W.; Memvanga, P.B. Green synthesis of antimicrobial silver nanoparticles using aqueous leaf extracts from three Congolese plant species (Brillantaisiapatula, Crossopteryxfebrifuga and Senna siamea). Heliyon 2020, 6, e04493. [Google Scholar] [CrossRef]
- Jeyaraj, M.; Gurunathan, S.; Qasim, M.; Kang, M.H.; Kim, J.H. A Comprehensive review on the synthesis, characterization, and biomedical application of platinum nanoparticles. Nanomaterials 2019, 9, 1719. [Google Scholar] [CrossRef]
- Hegazey, R.M.; Abdelrahman, E.A.; Kotp, Y.H.; Hameed, A.M.; Subaihi, A. Facile fabrication of hematite nanoparticles from Egyptian insecticide cans for efficient photocatalytic degradation of rhodamine B dye. J. Mater. Res. Technol. 2020, 9, 1652–1661. [Google Scholar] [CrossRef]
- Alharbi, A.; Abdelrahman, E.A. Efficient photocatalytic degradation of malachite green dye using facilely synthesized hematite nanoparticles from Egyptian insecticide cans. Spectrochim. Acta Part A Mol. Biomol. Spectrosc. 2020, 226, 117612. [Google Scholar] [CrossRef]
- Almehizia, A.A.; Al-Omar, M.A.; Naglah, A.M.; Bhat, M.A.; Al-Shakliah, N.S. Facile synthesis and characterization of ZnO nanoparticles for studying their biological activities and photocatalytic degradation properties toward methylene blue dye. Alex. Eng. J. 2021, 61, 2386–2395. [Google Scholar] [CrossRef]
- Zhao, B.; Mattelaer, F.; Rampelberg, G.; Dendooven, J.; Detavernier, C. Thermal and Plasma-Enhanced Atomic Layer Deposition of Yttrium Oxide Films and the Properties of Water Wettability. ACS Appl. Mater. Interfaces 2020, 12, 3179–3187. [Google Scholar] [CrossRef] [PubMed]
- Hare, J.I.; Lammers, T.; Ashford, M.B.; Puri, S.; Storm, G.; Barry, S.T. Challenges and strategies in anti-cancer nanomedicine development: An industry perspective. Adv. Drug Deliv. Rev. 2017, 108, 25–38. [Google Scholar] [CrossRef]
- Pirtarighat, S.; Ghannadnia, M.; Baghshahi, S. Green synthesis of silver nanoparticles using the plant extract of Salvia spinosa grown in vitro and their antibacterial activity assessment. J. Nanostruct. Chem. 2019, 9, 1–9. [Google Scholar] [CrossRef]
- Porosnicu, I.; Butnaru, C.M.; Tiseanu, I.; Stancu, E.; Munteanu, C.V.; Bita, B.I.; Duliu, O.G.; Sima, F. Y2O3 nanoparticles and X-ray radiation-induced effects in melanoma cells. Molecules 2021, 26, 3403. [Google Scholar] [CrossRef] [PubMed]
- Rajendran, A.; Alsawalha, M.; Alomayri, T. Biogenic synthesis of husked rice-shaped iron oxide nanoparticles using coconut pulp (Cocos nucifera L.) extract for photocatalytic degradation of Rhodamine B dye and their in vitro antibacterial and anticancer activity. J. Saudi Chem. Soc. 2021, 25, 101307. [Google Scholar] [CrossRef]
- Xu, J.; Zhu, J.; Niu, J.; Chen, M.; Yue, J. Efficient and stable photocatalytic hydrogen evolution activity of multi-hetero junction composite photocatalysts: CdS and NiS2 co-modified NaNbO3nanocubes. Front. Chem. 2020, 7, 880. [Google Scholar] [CrossRef]
- El-Sheekh, M.M.; Hassan, L.H.S.; Morsi, H.H. Assessment of the in vitro anticancer activities of cyanobacteria mediated silver oxide and gold nanoparticles in human colon CaCo-2 and cervical HeLa cells. Environ. Nanotechnol. Monit. Manag. 2021, 16, 100556. [Google Scholar] [CrossRef]
- Dixit, N.; Vaibhav, K.; Pandey, R.S.; Jain, U.K.; Katare, O.P.; Katyal, A.; Madan, J. Improved cisplatin delivery in cervical cancer cells by utilizing folate-grafted non-aggregated gelatin nanoparticles. Biomed. Pharmacother. 2015, 69, 1–10. [Google Scholar] [CrossRef]
- Benammar, I.; Salhi, R.; Deschanvres, J.L.; Maalej, R. The effect of rare earth element (Er, Yb) doping and heat treatment on suspension stability of Y2O3 nanoparticles elaborated by sol-gel method. J. Mater. Res. Technol. 2020, 9, 12634–12642. [Google Scholar] [CrossRef]
- Petoukhoff, C.E.; O’Carroll, D.M. Absorption-induced scattering and surface plasmon out-coupling from absorber-coated plasmonic metasurfaces. Nat. Commun. 2015, 6, 7899. [Google Scholar] [CrossRef] [PubMed][Green Version]
- Golovnev, N.N.; Molokeev, M.S.; Vereshchagin, S.N.; Atuchin, V.V. Calcium and strontium thiobarbiturates with discrete and polymeric structures. J. Coord. Chem. 2013, 66, 4119–4130. [Google Scholar] [CrossRef]
- Narasaiah, P.; Mandal, B.; Sarada, N.C. Biosynthesis of copper oxide nanoparticles from Drypetessepiaria leaf extract and their catalytic activity to dye degradation. In IOP Conference Series: Materials Science and Engineering; IOP Publishing: Bristol, UK, 2017; Volume 263, p. 022012. [Google Scholar] [CrossRef]
- Lin, L.; Starostin, S.A.; Li, S.; Khan, S.A.; Hessel, V. Synthesis of yttrium oxide nanoparticles via a facile microplasma-assisted process. Chem. Eng. Sci. 2018, 178, 157–166. [Google Scholar] [CrossRef]
- Golovnev, N.N.; Molokeev, M.S.; Vereshchagin, S.N.; Atuchin, V.V.; Sidorenko, M.Y.; Dmitrushkov, M.S. Crystal structure and properties of the precursor [Ni(H2O)6](HTBA)2·2H2O and the complexes M(HTBA)2(H2O)2 (M=Ni, Co, Fe). Polyhedron 2014, 70, 71–76. [Google Scholar] [CrossRef]
- Hajizadeh-Oghaz, M.; Razavi, R.S.; Barekat, M.; Naderi, M.; Malekzadeh, S.; Rezazadeh, M. Synthesis and characterization of Y2O3 nanoparticles by sol-gel process for transparent ceramics applications. J. Sol-Gel Sci. Technol. 2016, 78, 682–691. [Google Scholar] [CrossRef]
- Zaidi, Z.; Vaghasiya, K.; Vijay, A.; Sharma, M.; Verma, R.K.; Vaidya, S. Hollow ZnO from assembly of nanoparticles: Photocatalytic and antibacterial activity. J. Mater. Sci. 2018, 53, 14964–14974. [Google Scholar] [CrossRef]
- Mitra, R.N.; Merwin, M.J.; Han, Z.; Conley, S.M.; Al-Ubaidi, M.R.; Naash, M.I. Yttrium oxide nanoparticles prevent photoreceptor death in a light-damage model of retinal degeneration. Free. Radic. Biol. Med. 2014, 75, 140–148. [Google Scholar] [CrossRef]
- Kannan, S.K.; Sundararajan, M. Biosynthesis of yttrium oxide nanoparticles using Acalypha indica leaf extract. Bull. Mater. Sci. 2015, 38, 945–950. [Google Scholar] [CrossRef]
- Carbonin, S.; Menegazzo, G. Teaching application of an X-ray powder diffraction data card file: XRD profile simulation and Hanawalt index tabulation. Comput. Geosci. 1996, 22, 935–942. [Google Scholar] [CrossRef]
- Selvaraj, V.; Bodapati, S.; Murray, E.; Rice, K.M.; Winston, N.; Shokuhfar, T.; Zhao, Y.; Blough, E. Cytotoxicity and genotoxicity caused by yttrium oxide nanoparticles in HEK293 cells. Int. J. Nanomed. 2014, 9, 1379–1391. [Google Scholar] [CrossRef]
- Emami Nejad, A.; Najafgholian, S.; Rostami, A.; Sistani, A.; Shojaeifar, S.; Esparvarinha, M.; Nedaeinia, R.; Haghjooy Javanmard, S.; Taherian, M.; Ahmadlou, M.; et al. The role of hypoxia in the tumor microenvironment and development of cancer stem cell: A novel approach to developing treatment. Cancer Cell Int. 2021, 21, 62. [Google Scholar] [CrossRef] [PubMed]
- Chen, C.; Wang, X.; Binder, K.; Ghahremanpour, M.M.; van der Spoel, D.; Pöschl, U.; Su, H.; Cheng, Y. Energetic analysis of succinic acid in water droplets: Insight into the size-dependent solubility of atmospheric nanoparticles. Atmos. Chem. Phys. Discuss. 2021, 21, 1–19. [Google Scholar] [CrossRef]
- WijiPrasetyaningrum, P.; Bahtiar, A.; Hayun, H. Synthesis and Cytotoxicity Evaluation of Novel Asymmetrical Mono-Carbonyl Analogs of Curcumin (AMACs) against Vero, HeLa, and MCF7 Cell Lines. Sci. Pharm. 2018, 86, 25. [Google Scholar] [CrossRef] [PubMed]

Publisher’s Note: MDPI stays neutral with regard to jurisdictional claims in published maps and institutional affiliations. |
© 2022 by the authors. Licensee MDPI, Basel, Switzerland. This article is an open access article distributed under the terms and conditions of the Creative Commons Attribution (CC BY) license (https://creativecommons.org/licenses/by/4.0/).
Share and Cite
Govindasamy, R.; Govindarasu, M.; Alharthi, S.S.; Mani, P.; Bernaurdshaw, N.; Gomathi, T.; Ansari, M.A.; Alomary, M.N.; Atwah, B.; Malik, M.S.; et al. Sustainable Green Synthesis of Yttrium Oxide (Y2O3) Nanoparticles Using Lantana camara Leaf Extracts: Physicochemical Characterization, Photocatalytic Degradation, Antibacterial, and Anticancer Potency. Nanomaterials 2022, 12, 2393. https://doi.org/10.3390/nano12142393
Govindasamy R, Govindarasu M, Alharthi SS, Mani P, Bernaurdshaw N, Gomathi T, Ansari MA, Alomary MN, Atwah B, Malik MS, et al. Sustainable Green Synthesis of Yttrium Oxide (Y2O3) Nanoparticles Using Lantana camara Leaf Extracts: Physicochemical Characterization, Photocatalytic Degradation, Antibacterial, and Anticancer Potency. Nanomaterials. 2022; 12(14):2393. https://doi.org/10.3390/nano12142393
Chicago/Turabian StyleGovindasamy, Rajakumar, Mydhili Govindarasu, Salman S. Alharthi, Preeyanghaa Mani, Neppolian Bernaurdshaw, Thandapani Gomathi, Mohammad Azam Ansari, Mohammad N. Alomary, Banan Atwah, M. Shaheer Malik, and et al. 2022. "Sustainable Green Synthesis of Yttrium Oxide (Y2O3) Nanoparticles Using Lantana camara Leaf Extracts: Physicochemical Characterization, Photocatalytic Degradation, Antibacterial, and Anticancer Potency" Nanomaterials 12, no. 14: 2393. https://doi.org/10.3390/nano12142393
APA StyleGovindasamy, R., Govindarasu, M., Alharthi, S. S., Mani, P., Bernaurdshaw, N., Gomathi, T., Ansari, M. A., Alomary, M. N., Atwah, B., Malik, M. S., Rajeswari, V. D., Rekha, K., Ahmed, S. A., & Thiruvengadam, M. (2022). Sustainable Green Synthesis of Yttrium Oxide (Y2O3) Nanoparticles Using Lantana camara Leaf Extracts: Physicochemical Characterization, Photocatalytic Degradation, Antibacterial, and Anticancer Potency. Nanomaterials, 12(14), 2393. https://doi.org/10.3390/nano12142393

